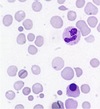

W24 - Leuk cases Flashcards
Acute promyelocytic leukaemia:
- is a subclass of ______
- genetic mutation is ___\_
- is an emergency because ________
Acute promyelocytic leukaemia:
- is a subclass of AML
- genetic mutation is t(15;17)
- is an emergency because quick deterioration + development of DIC
A 5-year-old boy of Indian ethnic origin presented with lymphadenopathy and a mediastinal mass on chest radiology
•WBC 180 × 109/l, Hb 93 g/l and platelet count 43 × 109/l
The most likely cause of the mediastinal mass is:
1) Thymoma
2) Acute myeloid leukaemia
3) Acute lymphoblastic leukaemia
4) Haemorrhage into the mediastinum
5) Pneumonia with a leukaemoid reaction

3) Acute lymphoblastic leukaemia - likely is a T-ALL
high WBC, low hb, low platelet = leukaemia with BM infiltration
mediastinal mass is the thymus infiltrated by T lymphoblasts
not 1) thymoma because this is rare and would suggest 2 pathology going on (thymoma + leukaemia) which is less likely
48-year-old male – railway engineer - attending A&E
- 2-week history bleeding gums
- Attended dentist - severe bleeding
- 1 episode of haematuria
- Minor bruising
- O/E: Left subconjunctival haemorrhage, small bruises over abdomen, no enlarged lymph nodes, no hepatosplenomegaly
What test is most likely to reveal the cause of the problem?
- Liver function tests
- Creatinine
- Coagulation screen
- Blood count, film and coagulation screen
- Blood count, film and coagulation screen
Blood film of someone with recent bleeding gums, hematuria, minor bruising, left subconjunctival haemorrhage, no enlarged LNs, no hepatosplenomegaly.
This is the blood film.
What do you see? Dignosis?

myeloid cells - granules with auer bodies.
Acute promyelocytic leukaemia
48-year-old male – railway engineer - attending A&E
- 2-week history bleeding gums
- 1 episode of haematuria
- Minor bruising
- O/E: Left subconjunctival haemorrhage, small bruises over abdomen, no enlarged lymph nodes, no hepatosplenomegaly
- Tests: normal renal function, minor liver derangement
FBC
- WBC 7.5 × 109/l (4.0‒11)
- Hb 109 g/l (130‒170)
- MCV 83 fl (83‒01)
- Platelets 21 × 109/l (120‒400)
Coagulation screen
- PT 13.4 s (9.6‒13.6)
- APTT 21.5 s (24‒32)
- Fibrinogen 0.97 g/l (1.8‒3.6)
Wht is the short APTT and low fibrinogen? what is the suspecting diagnosis?
Short APTT = activation of coagulation factors
low fibrinogen
= suspect DIC in background of leukaemia (likely Acute promyelocytic leukaemia)
A 68-year-old retired secretary:
- Gradual onset of fatigue, lethargy and exertional dyspnoea
- Non-smoker, not much alcohol, good diet
- O/E: Pallor (conjunctival and nail bed), mild ankle oedema
- Tests: WCC normal, Hb low, MCV high, neutrophil now, platelet normal, ferritin high.
- What (3) do you see? What do you do next?

- macrocytes present
- oval macrocytes/hypersegmented neutrophils absent (which could suggest vitB12/folate deficiency)
- hypochromic microcytes (suggests sideroblastic anaemia)
=> check serum B12, folte, LFTs, thyroid, + BM Aspirate
BM aspirate of 68 y.o. female with grdual onset fatigue, lethargy, exertional dyspnoea, and pallor:
what (2) do you see? diagnosis?

- Increased blast cells
- Ring sideroblasts (erythroblsts with iron loaded mitochondria)
Diagnosis = myelodysplastic syndrome (MDS)
A 72-year-old Indian woman
- Vegetarian, teetotal, non-smoker
- PC: SOB on exertion, fatigue, painful gums and tongue, unable to eat spicy food
- O/E: pallor only
- Bloods: WBC normal, Hb low, MCV high, platelet normal
What (3) does the blood film show? likely diagnosis?

- Hypersegmented neutrophil
- Macrocytes
- Oval macrocytes
Vitamin B12/folate deficiency
- A 70-year-old woman was referred to a vascular surgeon because of gangrenous toes. Breathless on exertion and morning cough.
- O/E: reduced femoral and distal pulses on side of affected toes, not breathless at rest, no cyanosis, plethora, conjunctival suffusion, spleen not felt
Which test do you do next? DDx?

Blood tests
Polycythaemia vera
Which of the following tests would be most useful to confirm the diagnosis of acute promyelocytic leukaemia?
1) Cytochemistry
2) Immunophenotyping
3) Cytogenetic analysis/FISH/molecular genetic analysis
3) Cytogenetic analysis/FISH/molecular genetic analysis
Megaloblast in the BM aspirate suggests…
Suspect pernicious anaemia => test anti-IF and anti-parietal cell abs
Megaloblastic anemia is a macrocytic anemia that is characterized by large RBC precursors (megaloblasts) in the bone marrow and that is usually caused by nutritional deficiencies of either folic acid (folate) or vitamin B12 (cobalamin)
What test would you do next to try to confirm PV?
1) Molecular analysis for JAK2 mutation
2) Measure total volume of red cells in circulation
3) Bone marrow aspirate and trephine biopsy
1) Molecular analysis for JAK2 mutation
Diagnosis of PV - How would you treat the patient?
1) Venesection alone
2) Imatinib
3) Venesection plus hydroxycarbamide
4) 432P
3) Venesection plus hydroxycarbamide (anti-metabolite)
Q on picture.

- Acute lymphoblastic leukaemia
- Chronic lymphocytic leukaemia
- HIV infection
- Infectious mononucleosis
- Whooping cough
2.Chronic lymphocytic leukaemia (CLL)
Q on picture.

RBC, Hb, Hct are high = polycythaemia
Qs to ask for figuring out the cause:
–Is it a true or a pseudo-polycythaemia?
–Is he hypoxic from chronic lung disease or cyanotic heart disease?
–Does he have inappropriate erythropoietin secretion from a cyst or tumour?
–Does he have an intrinsic bone marrow disease?
Q on slide. Choose from:

- Chronic myeloid leukaemia
- Polycythaemia vera
- Pseudo-polycythaemia
- Renal artery stenosis
- Smoking induced hypoxia
2. Polycythaemia vera
NB:
her RBC, hb, PCV are high
her WBC, neutrophil count, basophil count are high
her platelet count is high
= most likely PV
Q on slide.

Reactive neutrophilia
Q on slide.

CML
Think of 3 possibilities of brusiing in this child

- Non-accidental injury
- Coagulation abnormality (haemophilia)
- Thrombocytopenia (ALL, ITP)
FBC of North African woman with an 18 month old baby.
Hb 97 g/L
MCV low
MCH low
MCHC low
Blood film: microcytic hypochromic, some anistocytosis, some pencil cells (elongated red cells)
Most likely diagnosis?

Iron deficiency anaemia
NB: Its only a moderate anaemia and a moderate microcytosis. And elongated red cells fit in with IDA
What is this condition?
List 3 possible associated haematological abnormalities

Rheumatoid arthritis
- Anaemia of chronic disease
- IDA resulting from aspirin or NSAID use
- Neutropenia/thrombocytopaenia from drug toxicity
What tests (3) could you order to confirm polycythaemia vera?
- JAK2 V617F mutation
- BM spiration and trephine biopsy
- Serum erythropoietin
•A 21-year-old woman presented with abdominal pain, bruising and altered level of consciousness
- low grade fever, platelet count 15 x 10^9/L, bilirubin raised, LDH greatly raised, creatinine marginally raised
What is the nature of the anaemia?
What is the most likely diagnosis?
Name 2 other differential diagnoses?
What is the nature of the anaemia? Microangiopathic haemolytic anaemia (MAHA)
What is the most likely diagnosis? Thrombotic thrombocytopenic purpura (TTP)
differentials? HUS, meningococcal septicaemia


